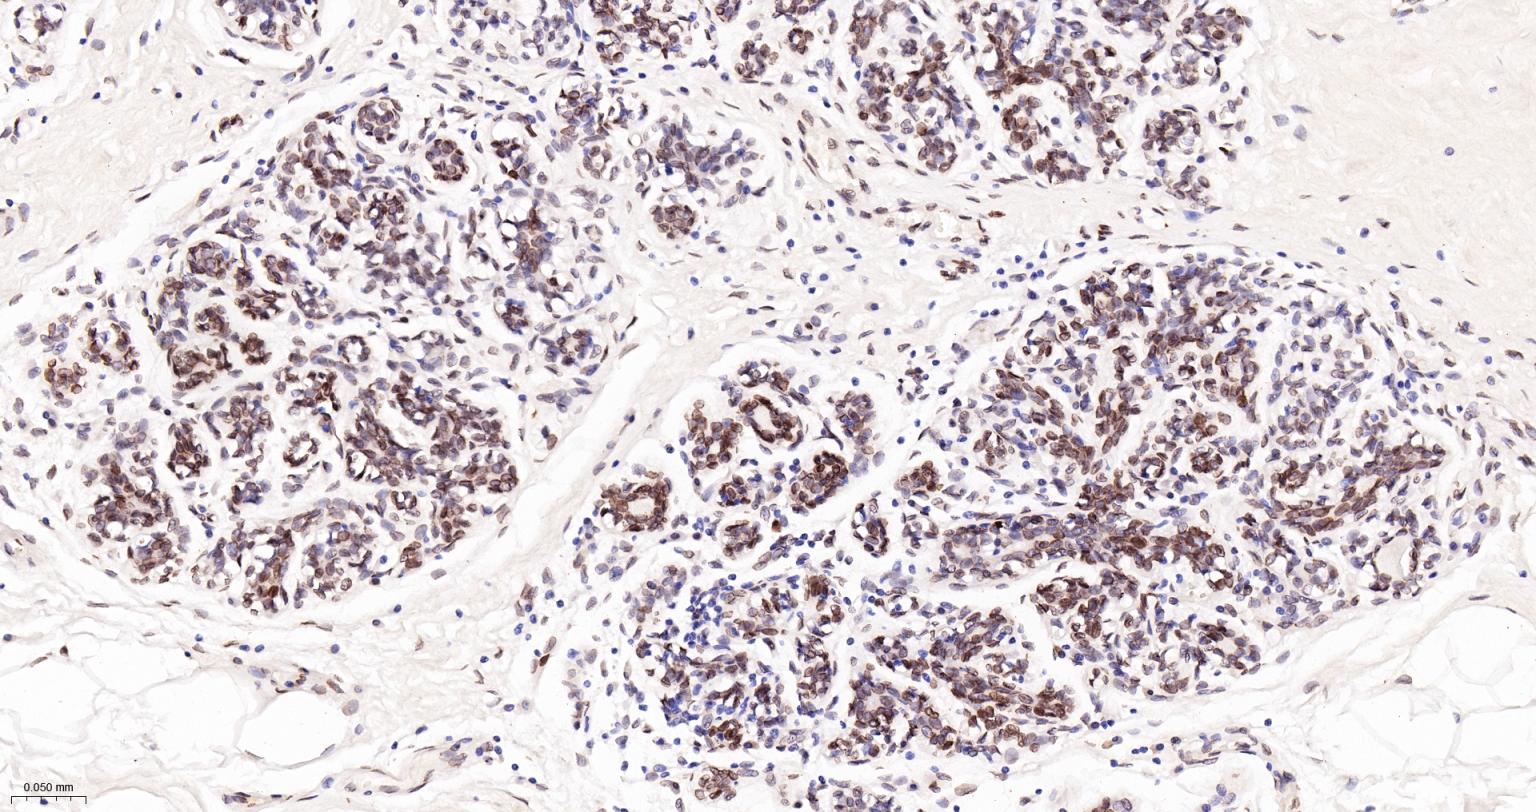
核纤层蛋白A/C单克隆抗体-bsm-51683M

Lamin A/C Mouse mAb (一抗) - WB,IHC-P,IHC-F,IF | Bioss

货号:bsm-51683M
产品详情
相关标记
相关产品
相关文献
常见问题
概述
产品编号
bsm-51683M
产品类型
mIHC精品抗体
英文名称
Lamin A/C Mouse mAb
中文名称
核纤层蛋白A/C单克隆抗体
英文别名
lamin-A; CDCD1; CDDC; CMD1A; CMT2B1; EMD2; FPL; FPLD; FPLD2; HGPS; IDC; LDP1; LFP; LGMD1B; LMN1; LMNC; LMNL1; MADA; PRO1; Dhe; LMNA_CHICK; LMNA; LMNA_HUMAN; LMNA_MOUSE; LMNA_PIG; LMNA_RAT;
抗体来源
Mouse
免疫原
Recombinant human Lamin A/C.
亚型
IgG1, k
性状
Liquid
纯化方法
affinity purified by Protein G
克隆类型
Monoclonal
克隆号
C3S4
理论分子量
73 kDa
检测分子量
65-70 kDa
浓度
1mg/ml
储存液
0.01M TBS (pH7.4) with 1% BSA, 0.02% Proclin300 and 50% Glycerol.
研究领域
SWISS
Gene ID
保存条件
Shipped at 4℃. Store at -20℃ for one year. Avoid repeated freeze/thaw cycles.
注意事项
This product as supplied is intended for research use only, not for use in human, therapeutic or diagnostic applications.
数据库链接
产品介绍
核膜标志物(Nuclear Envelope Marker)
核纤层蛋白(lamin) 是紧贴核内膜的一层厚度为20~50nm的纤维蛋白层或纤维网络。核纤层与细胞质骨架、核骨架连成一个整体,一般认为核纤层将核被膜和染色质提供了结构支架。有学者研究认为:lamin蛋白与细胞凋亡及衰老有关联,它包括:核纤层蛋白A、核纤层蛋白B、核纤层蛋白C几个不同亚型的蛋白。
核纤层蛋白(lamin) 是紧贴核内膜的一层厚度为20~50nm的纤维蛋白层或纤维网络。核纤层与细胞质骨架、核骨架连成一个整体,一般认为核纤层将核被膜和染色质提供了结构支架。有学者研究认为:lamin蛋白与细胞凋亡及衰老有关联,它包括:核纤层蛋白A、核纤层蛋白B、核纤层蛋白C几个不同亚型的蛋白。
背景资料
The nuclear lamina consists of a two-dimensional matrix of proteins located next to the inner nuclear membrane. The lamin family of proteins make up the matrix and are highly conserved in evolution. During mitosis, the lamina matrix is reversibly disassembled as the lamin proteins are phosphorylated. Lamin proteins are thought to be involved in nuclear stability, chromatin structure and gene expression. Vertebrate lamins consist of two types, A and B. Alternative splicing results in multiple transcript variants. Mutations in this gene lead to several diseases: Emery-Dreifuss muscular dystrophy, familial partial lipodystrophy, limb girdle muscular dystrophy, dilated cardiomyopathy, Charcot-Marie-Tooth disease, and Hutchinson-Gilford progeria syndrome. [provided by RefSeq, Apr 2012]

产品应用
| 应用 | 已检合格种属 | 预测种属 | 推荐稀释比例 |
|---|---|---|---|
| WB | Human, Mouse, Rat | 1:500-2000 | |
| IHC-P | Human, Rat | Mouse | 1:100-500 |
| IHC-F | Human, Rat | Mouse | 1:100-500 |
| IF | Human, Rat | Mouse | 1:100-500 |
交叉反应
交叉反应: Human, Mouse, Rat
相关产品
暂无相关产品
靶标
基因名
LMNA
蛋白名
Prelamin-A/C
亚基
Homodimer of lamin A and lamin C. Interacts with lamin-associated polypeptides IA, IB and TMPO-alpha, RB1 and with emerin. Interacts with SREBF1, SREBF2, SUN2 and TMEM43. Proteolytically processed isoform A interacts with NARF. Interacts with SUN1. Prelamin-A/C interacts with EMD. Interacts with MLIP; may regulate MLIP localization to the nucleus envelope. Interacts with DMPK; may regulate nuclear envelope stability.
亚细胞定位
Nucleus. Nucleus envelope. Note=Farnesylation of prelamin-A/C facilitates nuclear envelope targeting and subsequent cleaveage by ZMPSTE24/FACE1 to remove the farnesyl group produces mature lamin-A/C, which can then be inserted into the nuclear lamina. EMD is required for proper localization of non-farnesylated prelamin-A/C.
组织特异性
In the arteries, prelamin-A/C accumulation is not observed in young healthy vessels but is prevalent in medial vascular smooth muscle cells (VSMCs) from aged individuals and in atherosclerotic lesions, where it often colocalizes with senescent and degenerate VSMCs. Prelamin-A/C expression increases with age and disease. In normal aging, the accumulation of prelamin-A/C is caused in part by the down-regulation of ZMPSTE24/FACE1 in response to oxidative stress.
翻译后修饰
Increased phosphorylation of the lamins occurs before envelope disintegration and probably plays a role in regulating lamin associations.
Proteolytic cleavage of the C-terminal of 18 residues of prelamin-A/C results in the production of lamin-A/C. The prelamin-A/C maturation pathway includes farnesylation of CAAX motif, ZMPSTE24/FACE1 mediated cleavage of the last three amino acids, methylation of the C-terminal cysteine and endoproteolytic removal of the last 15 C-terminal amino acids. Proteolytic cleavage requires prior farnesylation and methylation, and absence of these blocks cleavage.
Sumoylation is necessary for the localization to the nuclear envelope.
Farnesylation of prelamin-A/C facilitates nuclear envelope targeting.
Proteolytic cleavage of the C-terminal of 18 residues of prelamin-A/C results in the production of lamin-A/C. The prelamin-A/C maturation pathway includes farnesylation of CAAX motif, ZMPSTE24/FACE1 mediated cleavage of the last three amino acids, methylation of the C-terminal cysteine and endoproteolytic removal of the last 15 C-terminal amino acids. Proteolytic cleavage requires prior farnesylation and methylation, and absence of these blocks cleavage.
Sumoylation is necessary for the localization to the nuclear envelope.
Farnesylation of prelamin-A/C facilitates nuclear envelope targeting.
疾病
Defects in LMNA are the cause of Emery-Dreifuss muscular dystrophy type 2, autosomal dominant (EDMD2) [MIM:181350]. A degenerative myopathy characterized by weakness and atrophy of muscle without involvement of the nervous system, early contractures of the elbows, Achilles tendons and spine, and cardiomyopathy associated with cardiac conduction defects.
Defects in LMNA are the cause of Emery-Dreifuss muscular dystrophy type 3, autosomal recessive (EDMD3) [MIM:181350].
Defects in LMNA are the cause of cardiomyopathy dilated type 1A (CMD1A) [MIM:115200]. Dilated cardiomyopathy is a disorder characterized by ventricular dilation and impaired systolic function, resulting in congestive heart failure and arrhythmia. Patients are at risk of premature death.
Defects in LMNA are the cause of familial partial lipodystrophy type 2 (FPLD2) [MIM:151660]; also known as familial partial lipodystrophy Dunnigan type. A disorder characterized by the loss of subcutaneous adipose tissue in the lower parts of the body (limbs, buttocks, trunk). It is accompanied by an accumulation of adipose tissue in the face and neck causing a double chin, fat neck, or cushingoid appearance. Adipose tissue may also accumulate in the axillae, back, labia majora, and intraabdominal region. Affected patients are insulin-resistant and may develop glucose intolerance and diabetes mellitus after age 20 years, hypertriglyceridemia, and low levels of high density lipoprotein cholesterol.
Defects in LMNA are the cause of limb-girdle muscular dystrophy type 1B (LGMD1B) [MIM:159001]. LGMD1B is an autosomal dominant degenerative myopathy with age-related atrioventricular cardiac conduction disturbances, dilated cardiomyopathy, and the absence of early contractures. LGMD1B is characterized by slowly progressive skeletal muscle weakness of the hip and shoulder girdles. Muscle biopsy shows mild dystrophic changes.
Defects in LMNA are the cause of Charcot-Marie-Tooth disease type 2B1 (CMT2B1) [MIM:605588]. CMT2B1 is a form of Charcot-Marie-Tooth disease, the most common inherited disorder of the peripheral nervous system. Charcot-Marie-Tooth disease is classified in two main groups on the basis of electrophysiologic properties and histopathology: primary peripheral demyelinating neuropathy or CMT1, and primary peripheral axonal neuropathy or CMT2. Neuropathies of the CMT2 group are characterized by signs of axonal regeneration in the absence of obvious myelin alterations, normal or slightly reduced nerve conduction velocities, and progressive distal muscle weakness and atrophy. CMT2B1 inheritance is autosomal recessive.
Defects in LMNA are the cause of Hutchinson-Gilford progeria syndrome (HGPS) [MIM:176670]. HGPS is a rare genetic disorder characterized by features reminiscent of marked premature aging. Note=HGPS is caused by the toxic accumulation of a mutant form of lamin-A/C. This mutant protein, called progerin, acts to deregulate mitosis and DNA damage signaling, leading to premature cell death and senescence. Progerin lacks the conserved ZMPSTE24/FACE1 cleavage site and therefore remains permanently farnesylated. Thus, although it can enter the nucleus and associate with the nuclear envelope, it cannot incorporate normally into the nuclear lamina.
Defects in LMNA are the cause of cardiomyopathy dilated with hypergonadotropic hypogonadism (CMDHH) [MIM:212112]. A disorder characterized by the association of genital anomalies, hypergonadotropic hypogonadism and dilated cardiomyopathy. Patients can present other variable clinical manifestations including mental retardation, skeletal anomalies, scleroderma-like skin, graying and thinning of hair, osteoporosis. Dilated cardiomyopathy is characterized by ventricular dilation and impaired systolic function, resulting in congestive heart failure and arrhythmia.
Defects in LMNA are the cause of mandibuloacral dysplasia with type A lipodystrophy (MADA) [MIM:248370]. A disorder characterized by mandibular and clavicular hypoplasia, acroosteolysis, delayed closure of the cranial suture, progeroide appearance, partial alopecia, soft tissue calcinosis, joint contractures, and partial lipodystrophy with loss of subcutaneous fat from the extremities. Adipose tissue in the face, neck and trunk is normal or increased.
Defects in LMNA are a cause of lethal tight skin contracture syndrome (LTSCS) [MIM:275210]; also known as restrictive dermopathy (RD). Lethal tight skin contracture syndrome is a rare disorder mainly characterized by intrauterine growth retardation, tight and rigid skin with erosions, prominent superficial vasculature and epidermal hyperkeratosis, facial features (small mouth, small pinched nose and micrognathia), sparse/absent eyelashes and eyebrows, mineralization defects of the skull, thin dysplastic clavicles, pulmonary hypoplasia, multiple joint contractures and an early neonatal lethal course. Liveborn children usually die within the first week of life. The overall prevalence of consanguineous cases suggested an autosomal recessive inheritance.
Defects in LMNA are the cause of heart-hand syndrome Slovenian type (HHS-Slovenian) [MIM:610140]. Heart-hand syndrome (HHS) is a clinically and genetically heterogeneous disorder characterized by the co-occurrence of a congenital cardiac disease and limb malformations.
Defects in LMNA are the cause of muscular dystrophy congenital LMNA-related (MDCL) [MIM:613205]. It is a form of congenital muscular dystrophy. Patients present at birth, or within the first few months of life, with hypotonia, muscle weakness and often with joint contractures.
Defects in LMNA are the cause of Emery-Dreifuss muscular dystrophy type 3, autosomal recessive (EDMD3) [MIM:181350].
Defects in LMNA are the cause of cardiomyopathy dilated type 1A (CMD1A) [MIM:115200]. Dilated cardiomyopathy is a disorder characterized by ventricular dilation and impaired systolic function, resulting in congestive heart failure and arrhythmia. Patients are at risk of premature death.
Defects in LMNA are the cause of familial partial lipodystrophy type 2 (FPLD2) [MIM:151660]; also known as familial partial lipodystrophy Dunnigan type. A disorder characterized by the loss of subcutaneous adipose tissue in the lower parts of the body (limbs, buttocks, trunk). It is accompanied by an accumulation of adipose tissue in the face and neck causing a double chin, fat neck, or cushingoid appearance. Adipose tissue may also accumulate in the axillae, back, labia majora, and intraabdominal region. Affected patients are insulin-resistant and may develop glucose intolerance and diabetes mellitus after age 20 years, hypertriglyceridemia, and low levels of high density lipoprotein cholesterol.
Defects in LMNA are the cause of limb-girdle muscular dystrophy type 1B (LGMD1B) [MIM:159001]. LGMD1B is an autosomal dominant degenerative myopathy with age-related atrioventricular cardiac conduction disturbances, dilated cardiomyopathy, and the absence of early contractures. LGMD1B is characterized by slowly progressive skeletal muscle weakness of the hip and shoulder girdles. Muscle biopsy shows mild dystrophic changes.
Defects in LMNA are the cause of Charcot-Marie-Tooth disease type 2B1 (CMT2B1) [MIM:605588]. CMT2B1 is a form of Charcot-Marie-Tooth disease, the most common inherited disorder of the peripheral nervous system. Charcot-Marie-Tooth disease is classified in two main groups on the basis of electrophysiologic properties and histopathology: primary peripheral demyelinating neuropathy or CMT1, and primary peripheral axonal neuropathy or CMT2. Neuropathies of the CMT2 group are characterized by signs of axonal regeneration in the absence of obvious myelin alterations, normal or slightly reduced nerve conduction velocities, and progressive distal muscle weakness and atrophy. CMT2B1 inheritance is autosomal recessive.
Defects in LMNA are the cause of Hutchinson-Gilford progeria syndrome (HGPS) [MIM:176670]. HGPS is a rare genetic disorder characterized by features reminiscent of marked premature aging. Note=HGPS is caused by the toxic accumulation of a mutant form of lamin-A/C. This mutant protein, called progerin, acts to deregulate mitosis and DNA damage signaling, leading to premature cell death and senescence. Progerin lacks the conserved ZMPSTE24/FACE1 cleavage site and therefore remains permanently farnesylated. Thus, although it can enter the nucleus and associate with the nuclear envelope, it cannot incorporate normally into the nuclear lamina.
Defects in LMNA are the cause of cardiomyopathy dilated with hypergonadotropic hypogonadism (CMDHH) [MIM:212112]. A disorder characterized by the association of genital anomalies, hypergonadotropic hypogonadism and dilated cardiomyopathy. Patients can present other variable clinical manifestations including mental retardation, skeletal anomalies, scleroderma-like skin, graying and thinning of hair, osteoporosis. Dilated cardiomyopathy is characterized by ventricular dilation and impaired systolic function, resulting in congestive heart failure and arrhythmia.
Defects in LMNA are the cause of mandibuloacral dysplasia with type A lipodystrophy (MADA) [MIM:248370]. A disorder characterized by mandibular and clavicular hypoplasia, acroosteolysis, delayed closure of the cranial suture, progeroide appearance, partial alopecia, soft tissue calcinosis, joint contractures, and partial lipodystrophy with loss of subcutaneous fat from the extremities. Adipose tissue in the face, neck and trunk is normal or increased.
Defects in LMNA are a cause of lethal tight skin contracture syndrome (LTSCS) [MIM:275210]; also known as restrictive dermopathy (RD). Lethal tight skin contracture syndrome is a rare disorder mainly characterized by intrauterine growth retardation, tight and rigid skin with erosions, prominent superficial vasculature and epidermal hyperkeratosis, facial features (small mouth, small pinched nose and micrognathia), sparse/absent eyelashes and eyebrows, mineralization defects of the skull, thin dysplastic clavicles, pulmonary hypoplasia, multiple joint contractures and an early neonatal lethal course. Liveborn children usually die within the first week of life. The overall prevalence of consanguineous cases suggested an autosomal recessive inheritance.
Defects in LMNA are the cause of heart-hand syndrome Slovenian type (HHS-Slovenian) [MIM:610140]. Heart-hand syndrome (HHS) is a clinically and genetically heterogeneous disorder characterized by the co-occurrence of a congenital cardiac disease and limb malformations.
Defects in LMNA are the cause of muscular dystrophy congenital LMNA-related (MDCL) [MIM:613205]. It is a form of congenital muscular dystrophy. Patients present at birth, or within the first few months of life, with hypotonia, muscle weakness and often with joint contractures.
相似性
Belongs to the intermediate filament family.
功能
Lamins are components of the nuclear lamina, a fibrous layer on the nucleoplasmic side of the inner nuclear membrane, which is thought to provide a framework for the nuclear envelope and may also interact with chromatin. Lamin A and C are present in equal amounts in the lamina of mammals. Play an important role in nuclear assembly, chromatin organization, nuclear membrane and telomere dynamics.
同靶标产品
相关文献
提示: 发表研究结果有使用 bsm-51683M 时请让我们知道,以便我们可以引用参考文章。作为回馈,资料提供者将获得我们送上的小礼品。